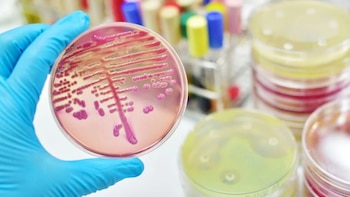
Bacteria Klebsiella pneumoniae: dónde circula

Antonio Resines, primeras palabras tras su ingreso hospitalario durante una semana: "Estoy estupendamente"
El intérprete madrileño fue dado de alta tras permanecer varios días en cuidados intensivos, recibe apoyo familiar mientras se recupera y opta por la cautela respecto a la reanudación de sus proyectos televisivos, aunque asegura sentirse bien

De Loles León, a Carmen Machi. El mundo del cine da la última hora sobre el estado de Antonio Resines tras su ingreso
Compañeros cercanos expresan alivio por la evolución positiva del actor, quien ya descansa en su hogar tras permanecer en cuidados intensivos y hospitalización, mientras figuras del cine destacan su energía, espíritu resiliente y carácter indestructible

Jennifer Pedraza ganó batalla jurídica: Supersalud tendrá que darle información sobre esposa del ministro Guillermo Alfonso Jaramillo
La representante a la Cámara, declarada en oposición al Gobierno de Gustavo Petro, le sigue la pista a las actuaciones de Beatriz Gómez Consuegra, cónyuge del titular de la cartera de Salud, que se habría extralimitado en sus funciones en el conocido caso del buque hospital en el Amazonas

Cómo sigue la salud del padre de Nairo Quintana tras accidente de tránsito: Hospital San Rafael de Tunja emitió comunicado oficial
El hombre colisionó contra un camión en la vía Tunja - Arcabuco, al parecer por una imprudencia que está siendo investigada por las autoridades

Bebé nació en un taxi en la vía entre Madrid y Facatativá: el conductor tuvo que hacer las veces de médico
En las redes sociales, además de mostrar el hecho, los usuarios comentaron los problemas frecuentes en la atención en el hospital de Madrid. El taxista llevó a la madre y su pequeño hasta otro centro de salud

Tragedia enluta a la población tolimense: adulto mayor murió tras ser arrollado por un tractor
El abuelito se encontraba adelantando sus labores en el momento en el que ocurrió el accidente

Hombre que fue quemado químicamente, presuntamente por su expareja, necesita donaciones de sangre en el Tolima
Las autoridades de salud buscan donantes para ayudar en las múltiples transfusiones necesarias tras el grave ataque y quemaduras sufridas por Parra Vega

Hombre incendió su casa y recibió a los bomberos a golpes para evitar ser rescatado
El sujeto se quedó al interior de su vivienda en llamas y no quería ser rescatado por las autoridades

Oferta de servicios de UCI pediátricas está mal distribuida en Bogotá, advirtió la Personería Distrital
El órgano de control exigió mejorar la oferta en sectores de la capital, donde hay muchos niños, pero pocas unidades de cuidado intensivo pediátricas para atenderlos

Bacteria Klebsiella pneumoniae: dónde circula la infección en Colombia
Desde las directivas de uno de los centros médicos más importantes del país se mencionó que tres pacientes están en aislamiento
Últimas Noticias
Sindicato y empleador: Causas de los conflictos laborales
El documento detalla que los tipos de desacuerdo laboral se generan por malentendidos o problemas en la comunicación, sobre los roles y las responsabilidades, cuestionamientos sobre liderazgo y gestión, entre otros

Elecciones primarias en Perú se realizan este domingo: ¿Cuándo se conocerán los resultados proclamados por el JNE?
Este domingo, treinta y siete organizaciones políticas de Perú participan en elecciones primarias internas mediante delegados, dando inicio a la carrera electoral que culminará en 2026 con la renovación de autoridades nacionales, regionales y municipales

Estos son los chats que implicarían al Ministerio de Hacienda en el escándalo de la Ungrd: varios funcionarios habrían recibido presiones y chantajes
Un extenso intercambio de mensajes privados muestra cómo dos colaboradoras del Ministerio de Hacienda discutieron sobre presuntos chantajes, disputas políticas y el impacto de las investigaciones judiciales en la estabilidad institucional de Colombia

Así fue la reacción del elenco de “Stranger Things” ante el impactante giro de Will Byers
La sorpresa de los actores quedó registrada durante la lectura de guion tras conocer el final del primer volumen

Caos en el aeropuerto Jorge Chávez: colas y quejas de pasajeros de vuelos internacionales por el cobro de la TUUA
Las filas y la falta de información marcaron la mañana de este domingo 7 de diciembre en la zona de conexiones, donde numerosos viajeros de Argentina, Chile y México expresaron su rechazo a la nueva tarifa
